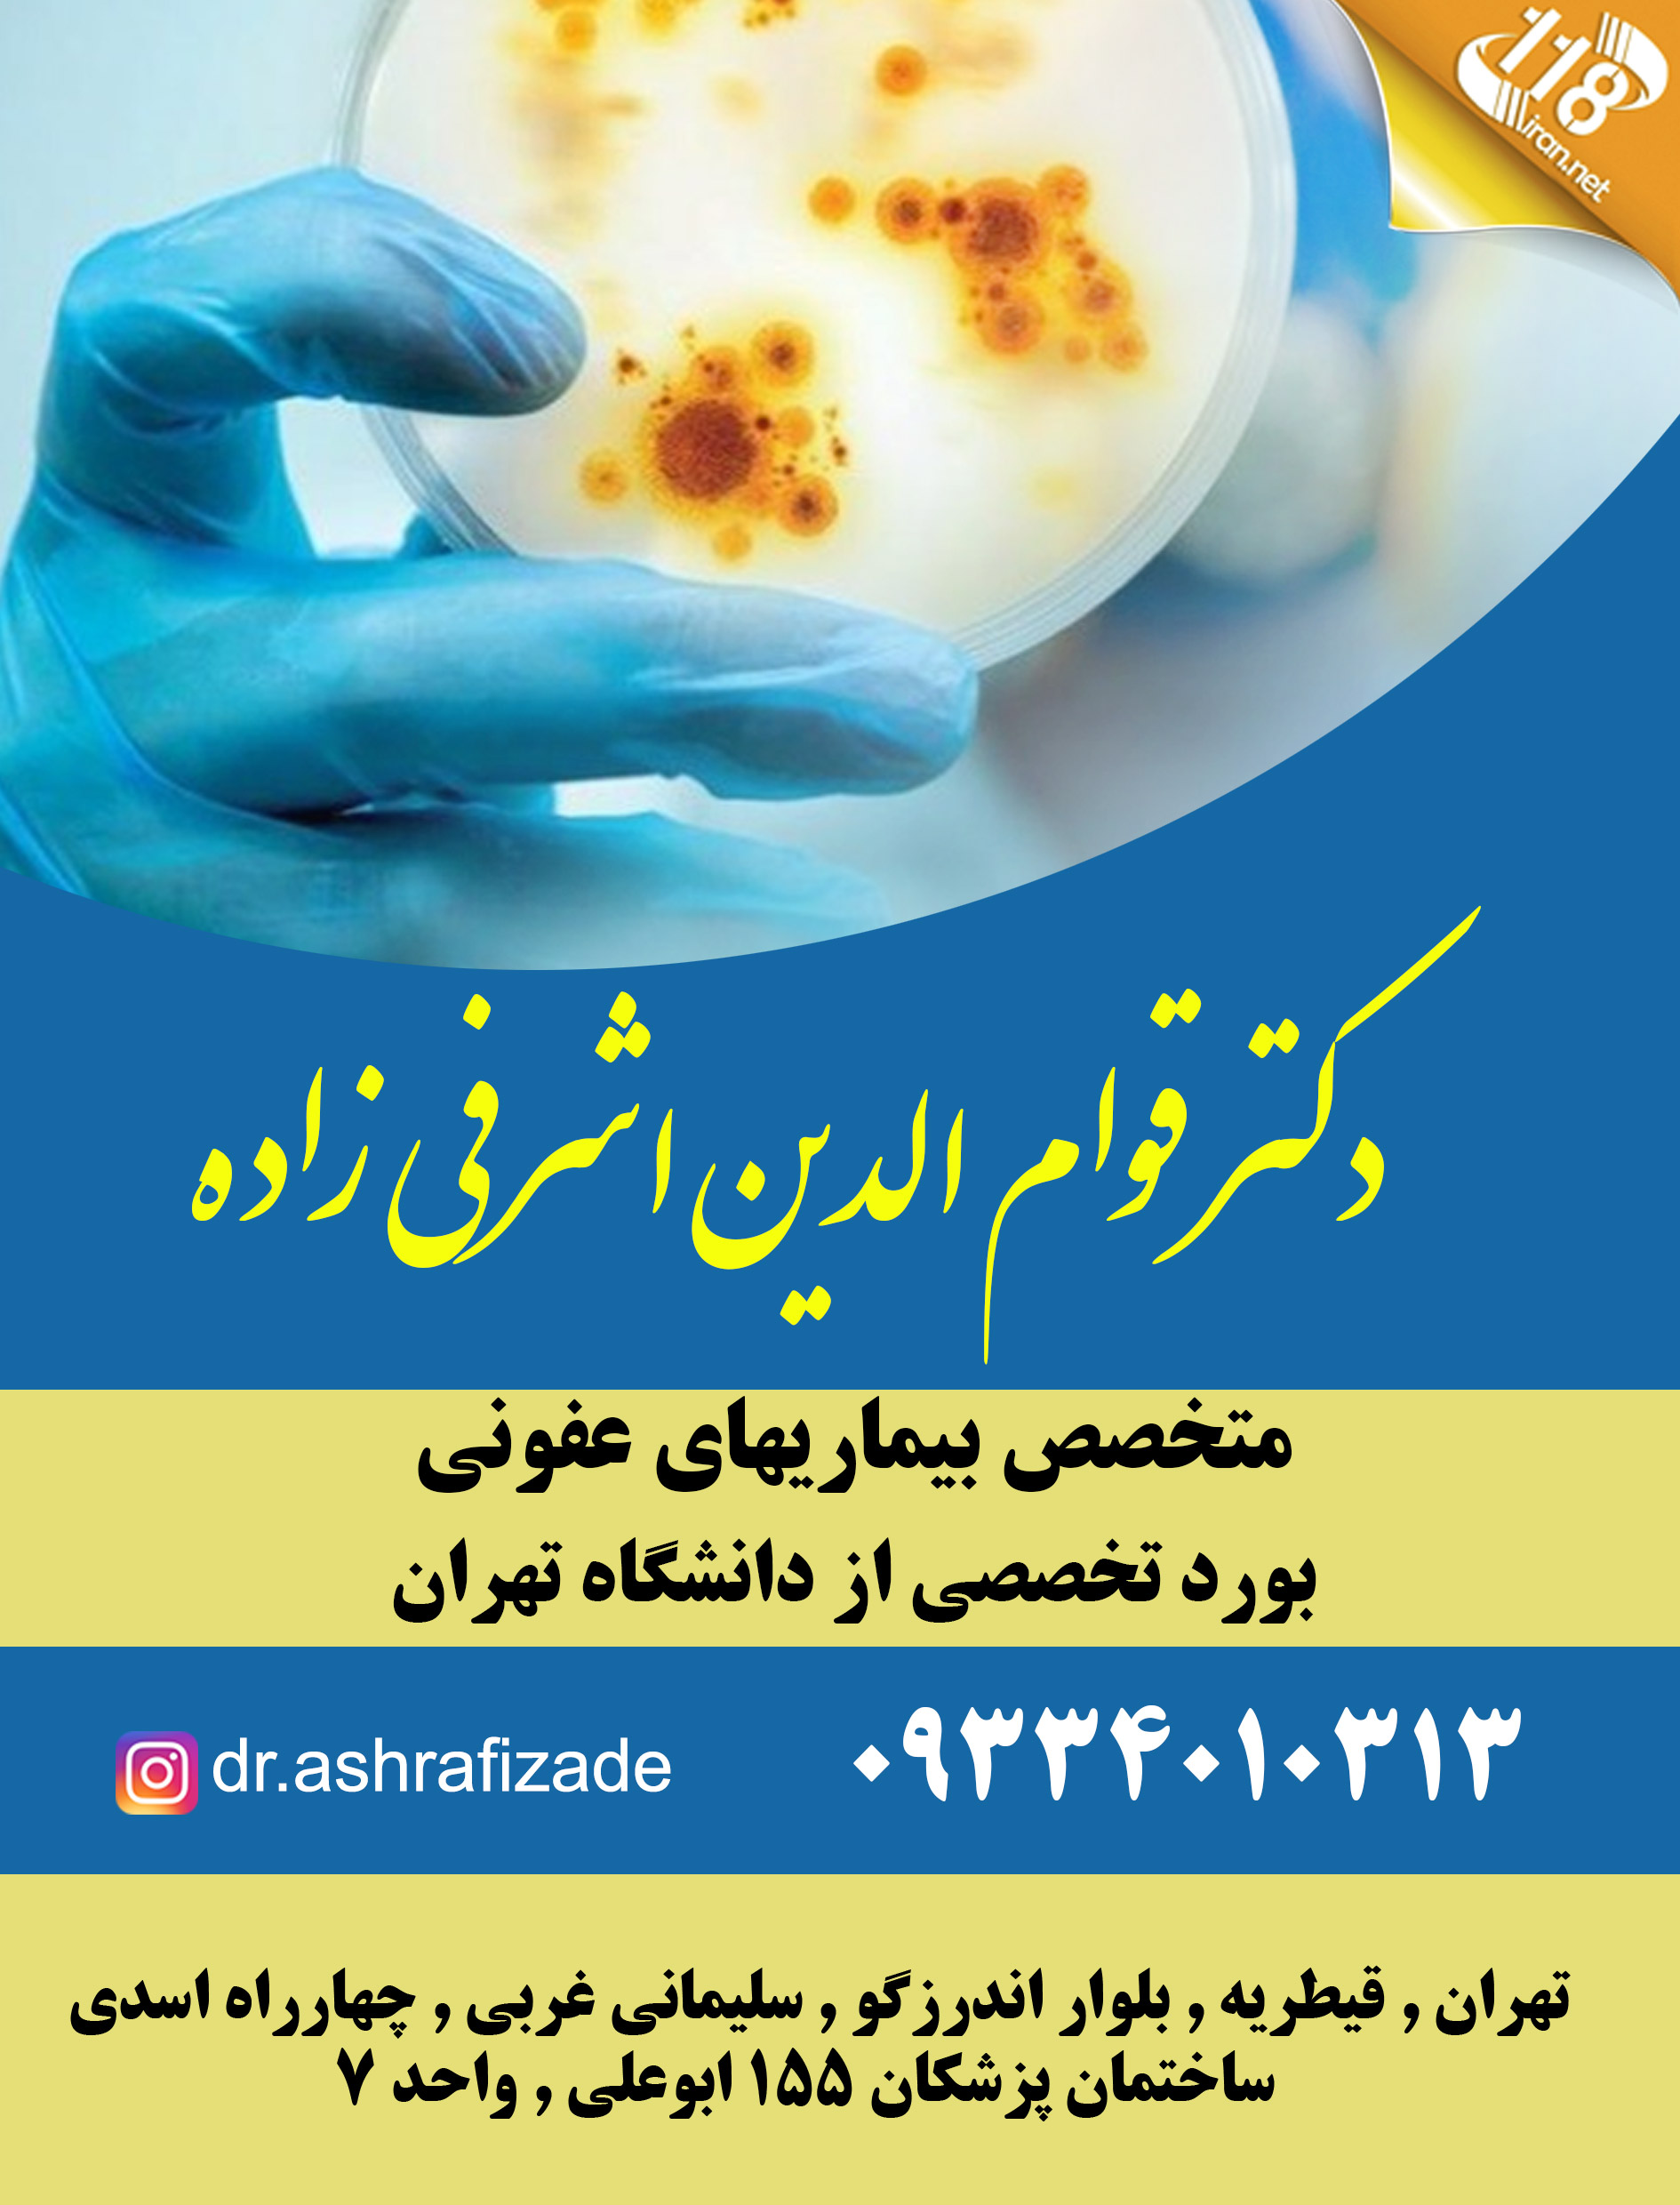

توضیحات آگهی
دکتر قوام الدین اشرفی زاده در تهران
نوع فعالیت:
دکتر قوام الدین اشرفی زاده در تهران
متخصص بیماریهای عفونی
بورد تخصصی از دانشگاه تهران
شرح خدمات:
بیماریهای منتقله از راه جنسی
تبخال تناسلی
زگیل تناسلی
ایدز،هپاتیت
پذیرش بیماران مبتلا به کرونا یا کووید ۱۹
پذیرش:
مطب شنبه الی پنجشنبه ۱۶ الی ۲۰
تماس:
اینستاگرام:
آدرس:
ویدیو:
توضیحات بیشتر:
دکتر قوام الدین اشرفی زاده در تهران
عفونت های زنان
عفونت های کلیه و مجاری ادراری
عفونت ها و بیماریهای گوارشی
عفونت های تنفسی و سینوزیت
بیماریهای تب دار
زخم های مزمن( زخم بستر و دیابتیک)
متخصص عفونی پزشکی است که در زمینه تشخیص، کنترل و درمان عفونتهای مزمن، پیچیده یا خطرناک تخصص دارد. این متخصص به نوعی کارآگاه ارگانیسمهای بدن هم هست و تلاش میکند که با استفاده از شرححال بیمار یا نتایج تستهای آزمایشگاهی، بیماریهای عفونی را تشخیص بدهد و درمان کند.
حوزه ی درمانی پزشکان متخصص عفونی چیست؟
دلایلی که پزشک عمومی ممکن است شما را به متخصص عفونی ارجاع دهد شامل موارد زیر است:
عفونت هایی که نسبت به درمان (به عنوان مثال آنتی بیوتیک) مقاوم هستند
تشخیص عفونت دشوار است
عفونت با تب بالا همراه است
ارزیابی های پیش از سفرهای بین المللی
بیماری بعد از مسافرت
HIV / ایدز
هپاتیت B و C
دکتر قوام الدین اشرفی زاده در تهران
متخصص عفونی کیست؟
پزشک بیماریهای عفونی یا متخصص عفونی، پزشکی است که در زمینۀ بیماریهای عفونی تخصص دارد. ارگانیسمهای مضری که وارد بدن میشوند بیماریهای عفونی را ایجاد میکنند. ویروسها، باکتریها، قارچها و انگلها رایجترین علل این بیماریها محسوب میشوند. این ارگانیسمها در هر جایی حضور دارند و در بیشتر موارد برخی از آنها بدون ایجاد هرگونه مشکلی در کنار ما زندگی میکنند. با این حال ممکن است بیماریهایی را ایجاد کنند که شدت آنها از خفیف تا خطرناک متفاوت است. بیماریهای عفونی معمولاً مسری هستند و از طریق غذا، خاک و آب آلوده و همچنین نیش حشرات و حیوانات منتقل میشوند. این بیماریها ممکن است پوست، دستگاه ادرار، ریهها، خون و تقریباً هر ناحیهای از بدن را درگیر کنند.
بیماریهای عفونی در سرتاسر جهان بسیار رواج دارند؛ اما شیوع برخی از بقیه بیماریها بیشتر است. آنفولانزا، سرخک، سرماخوردگی، گلودرد استرپتوکوکی، کووید-19 و سالمونلا مثالهایی از بیماریهای عفونی بهشدت رایج محسوب میشوند. بعد از هر بار ابتلا به عفونت یا ویروس، لازم نیست به دیدن پزشک متخصص عفونی بروید؛ چون بیشتر پزشکان میتوانند عفونتها و ویروسهای رایج را درمان کنند. متخصص عفونی پزشکی است که در زمینه تشخیص، کنترل و درمان عفونتهای مزمن، پیچیده یا خطرناک تخصص دارد. این متخصص به نوعی کارآگاه ارگانیسمهای بدن هم هست و تلاش میکند که با استفاده از شرححال بیمار یا نتایج تستهای آزمایشگاهی، بیماریهای عفونی را تشخیص بدهد و درمان کند.
دکتر قوام الدین اشرفی زاده در تهران






نقد و بررسیها
هنوز بررسیای ثبت نشده است.